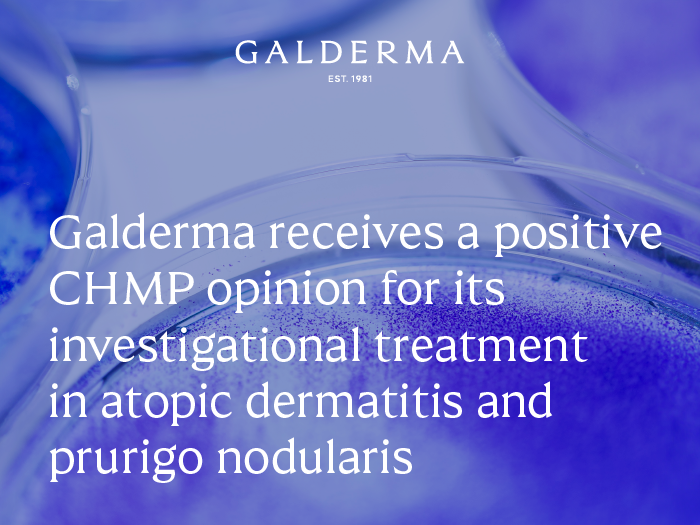

CHMP recommends approval of Galderma’s nemolizumab for moderate-to-severe atopic dermatitis and prurigo nodularis in the European Union
- Atopic dermatitis is a common, chronic, and flaring inflammatory skin disease characterized by persistent itch and recurrent skin lesions, and affects approximately up to 40 million people in the European Union (EU)1-4
- Prurigo nodularis is a serious skin disease characterized by chronic itch, skin nodules covering large body areas, and poor sleep quality, which is estimated to affect up to 111 people per 100,000 in the EU5-10
- Nemolizumab is a first-in-class monoclonal antibody that specifically targets IL-31 receptor alpha, inhibiting the signaling of IL-31.2 IL-31 is a neuroimmune cytokine that drives itch and is involved in inflammation and skin barrier dysfunction in both atopic dermatitis and prurigo nodularis11-13
- This positive opinion from the European Medicines Agency (EMA)’s Committee for Medicinal Products for Human Use (CHMP) recommending the granting of marketing authorization of nemolizumab in the European Union (EU) for the treatment of both atopic dermatitis and prurigo nodularis follows the United States Food and Drug Administration’s approval of nemolizumab for the treatment of adults with prurigo nodularis earlier in August 202414
Zug, Switzerland – December 13, 2024 – Galderma today announced that the Committee for Medicinal Products for Human Use (CHMP) of the European Medicines Agency (EMA) has adopted a positive opinion and recommended granting the marketing authorization of nemolizumab for the treatment of both atopic dermatitis and prurigo nodularis in the European Union (EU). The CHMP has recommended nemolizumab’s approval for subcutaneous use for the treatment of moderate-to-severe atopic dermatitis in patients aged 12 years and older who are candidates for systemic therapy, and for subcutaneous use for the treatment of adults with moderate-to-severe prurigo nodularis who are candidates for systemic therapy. This follows its approval for the treatment of adults with prurigo nodularis by the United States (U.S.) Food and Drug Administration (FDA) in August 2024.14
Atopic dermatitis is a common, chronic, and flaring inflammatory skin disease which affects approximately 10 to 40 million people in the EU, with up to 66% of adults suffering with a moderate-to-severe form of the condition.1-4,15 Often reported as one of patients’ most problematic symptoms, 87% of people with atopic dermatitis say they are seeking freedom from itch, with speed of itch relief therefore also prioritized by both patients and physicians.16-19 Atopic dermatitis is also a highly heterogenous disease and can be associated with several comorbid conditions, namely mental health disorders and other autoimmune- or immune-mediated diseases.20,21
Prurigo nodularis is a serious skin condition characterized by several debilitating symptoms, including chronic itch, skin nodules covering large body areas, and poor sleep quality.5-7,10 The condition is underrecognized and underdiagnosed, and its prevalence is not well-documented, but it is estimated to affect between 7-111 people per 100,000 in the EU depending on the country.8,9,12
Given the significant burden these serious diseases place on patients, their families, and caregivers, there is a need for alternative treatment options that may effectively relieve the signs and symptoms.22,23
“The robust evidence base we have built for nemolizumab in both atopic dermatitis and prurigo nodularis shows the extent of its potential in improving outcomes for these diseases where the burden and unmet needs remain high. We now await the European Commission’s approval decision and hope to be able to bring nemolizumab to patients in the European Union in due course.”
FLEMMING ØRNSKOV, M.D., MPH
CHIEF EXECUTIVE OFFICER
GALDERMA
This positive CHMP opinion is based on robust results from the phase III ARCADIA and OLYMPIA clinical trial programs in atopic dermatitis and prurigo nodularis, respectively.
The phase III ARCADIA 1 and 2 trials evaluated the efficacy and safety of nemolizumab in 1,728 adolescent and adult patients with moderate-to-severe atopic dermatitis. Results demonstrated that patients treated with nemolizumab, administered subcutaneously every four weeks in combination with background topical corticosteroids (TCS), with or without topical calcineurin inhibitors (TCI), showed statistically significant improvements in co-primary and key secondary endpoints, when compared to placebo in combination with TCS, with or without TCI, after 16 weeks of treatment, with significant itch relief observed as early as Week 1.24
The phase III OLYMPIA 1 and 2 trials evaluated the efficacy and safety of nemolizumab administered subcutaneously every four weeks in more than 500 patients with prurigo nodularis. The trials met both their primary and key secondary endpoints, demonstrating that treatment with nemolizumab resulted in significant and clinically meaningful improvements in itch and skin nodules at Week 16, with rapid reductions in itch observed as early as Week 4.25,26
Nemolizumab was well tolerated in both trials, and its safety profile was generally consistent with earlier data, and between trials.24-26
The positive CHMP opinion will now be sent to the European Commission for the adoption of a decision on an EU-wide marketing authorization. If approved, nemolizumab would be the first monoclonal antibody treatment available for patients in the EU that specifically targets IL-31 receptor alpha, inhibiting the signaling of IL-31.2 IL-31 is a neuroimmune cytokine that drives itch and is involved in inflammation and skin barrier dysfunction in both atopic dermatitis and prurigo nodularis.11-13
“This positive opinion represents an encouraging step forward for patients in the EU with atopic dermatitis and prurigo nodularis, given the profound impact these conditions have on the lives of patients and their loved ones. With unrelenting itch, accompanied by skin lesions as well as potential mental health implications, new treatment options that have the potential to quickly and effectively treat these conditions are essential.”
PROFESSOR DIAMANT THAÇI
LEAD INVESTIGATOR OF THE ARCADIA LONG-TERM EXTENSION STUDY
UNIVERSITY OF LUBECK, GERMANY
This positive opinion from the CHMP follows the U.S. FDA’s approval of nemolizumab (marketed as Nemluvio®) as a pre-filled pen for subcutaneous injection for the treatment of adults with prurigo nodularis in August 2024.14 The U.S. FDA’s review of Galderma’s Biologics License Application for nemolizumab for the treatment of moderate-to-severe atopic dermatitis is currently ongoing, with a decision anticipated soon. Galderma also has marketing authorization applications for nemolizumab in both atopic dermatitis and prurigo nodularis under review by multiple additional regulatory authorities, including via the Access Consortium framework in countries such as Australia, Singapore, and Switzerland, as well as in Canada, Brazil, and South Korea. Further submissions to other regulatory authorities will continue throughout the coming months.
Media can find more information about atopic dermatitis and prurigo nodularis here.
About nemolizumab
Nemolizumab was initially developed by Chugai Pharmaceutical Co., Ltd. In 2016, Galderma obtained exclusive rights to the development and marketing of nemolizumab worldwide, except in Japan and Taiwan. In Japan, nemolizumab is marketed as Mitchga® and is approved for the treatment of prurigo nodularis, as well as pruritus associated with atopic dermatitis in pediatric, adolescent, and adult patients.27,28
About the OLYMPIA clinical trial program25,26,29,30
The OLYMPIA program included two identically designed, pivotal phase III clinical trials which enrolled 560 patients – OLYMPIA 1 and OLYMPIA 2. This is the largest clinical trial program conducted in prurigo nodularis to date, and the only program to include a long-term extension study.
These global, randomized, double-blind, placebo-controlled phase III clinical trials assessed the efficacy and safety of nemolizumab monotherapy compared with placebo in patients at least 18 years of age with moderate-to-severe prurigo nodularis over a 16- or 24-week treatment period for OLYMPIA 2 and OLYMPIA 1, respectively.
About prurigo nodularis
Prurigo nodularis is a chronic, debilitating, and distinct neuroimmune skin disease characterized by the presence of intense itch and thick skin nodules covering large body areas.6 The majority of patients report that the persistent itch negatively impacts their quality of life.31 Furthermore, the intense itch associated with prurigo nodularis results in significant sleep disturbance and further contributes to reduced quality of life.10,32
About the ARCADIA clinical trial program24,33,34
The ARCADIA program included two identically designed, pivotal phase III clinical trials, which enrolled more than 1,700 patients – ARCADIA 1 and ARCADIA 2.
These global, randomized, multicenter, double-blind, placebo-controlled phase III clinical trials, evaluated the efficacy and safety of nemolizumab administered subcutaneously every four weeks compared to placebo (both administered with background topical corticosteroids with or without topical calcineurin inhibitors).
The trials were conducted in adolescent and adult patients (12 years and over) with moderate-to-severe atopic dermatitis for an initial treatment phase of 16 weeks. Patients who responded to treatment (defined as patients who achieved an investigator’s global assessment score of clear (0) or almost clear (1), or a 75% or greater improvement in the eczema area and severity index score) were then re-randomized to a maintenance treatment phase for up to 48 weeks.
About atopic dermatitis
Atopic dermatitis is a common, chronic, and flaring inflammatory skin disease, characterized by persistent itch and recurrent skin lesions.1-3 It is the most common inflammatory skin disease, impacting almost four times more people than psoriasis.2,3,35 While currently available treatments may improve some signs and symptoms of the disease, many patients do not respond optimally to approved therapies and do not experience itch relief and clear skin to the same degree.2,13,23,36
About Galderma
Galderma (SIX: GALD) is the pure-play dermatology category leader, present in approximately 90 countries. We deliver an innovative, science-based portfolio of premium flagship brands and services that span the full spectrum of the fast-growing dermatology market through Injectable Aesthetics, Dermatological Skincare and Therapeutic Dermatology. Since our foundation in 1981, we have dedicated our focus and passion to the human body’s largest organ – the skin – meeting individual consumer and patient needs with superior outcomes in partnership with healthcare professionals. Because we understand that the skin we are in shapes our lives, we are advancing dermatology for every skin story. For more information: www.galderma.com.
For further information:
|
Christian Marcoux, M.Sc. Chief Communications Officer christian.marcoux@galderma.com +41 76 315 26 50 |
Emil Ivanov Head of Strategy, Investor Relations, and ESG +41 21 642 78 12
|
|
Sébastien Cros Corporate Communications Director +41 79 529 59 85 |
Jessica Cohen Investor Relations and Strategy Director +41 21 642 76 43 |
References:
- Yang G, et al. Skin Barrier Abnormalities and Immune Dysfunction in Atopic Dermatitis. Int J Mol Sci. 2020;21(8):2867. doi: https://doi.org/10.3390/ijms21082867
- Langan SM, et al. Atopic dermatitis [published correction appears in Lancet. 2020;396(10253):758]. Lancet. 2020;396(10247):345-360. doi:10.1016/S0140- 6736(20)31286-1
- Ständer S. Atopic dermatitis. N Engl J Med. 2021;384(12):1136-1143. doi:10.1056/NEJMra2023911
- Luger, T, et al. Clinical and Humanistic Burden of Atopic Dermatitis in Europe: Analyses of the National Health and Wellness Survey. Dermatol Ther (Heidelb). 12, 949–969 (2022). https://doi.org/10.1007/s13555-022-00700-6
- Huang AH, et al. Prurigo nodularis: epidemiology and clinical features. J Am Acad Dermatol. 2020;83(6):1559-1565. doi:10.1016/j.jaad.2020.04.183
- Pereira MP, et al. European Academy of Dermatology and Venereology European prurigo project: expert consensus on the definition, classification and terminology of chronic prurigo. J Eur Acad Dermatol Venereol. 2018;32(7):1059-1065. doi:10.1111/jdv.14570
- Ständer S, et al. IFSI-guideline on chronic prurigo including prurigo nodularis. Itch. 2020;5(4):e42. doi:10.1097/itx.0000000000000042
- Ryczek A, et al. Prevalence of Prurigo Nodularis in Poland. Acta Derm Venereol. 100: adv00155 (2020).
- Ständer, S, et al. Epidemiology of Prurigo Nodularis compared with Psoriasis in Germany: A Claims Database Analysis. Acta Dermato-Venereologica. 100(18), 1–6 (2020). https://doi.org/10.2340/00015555-3655
- Joel MZ, et al. Risk of itch-induced sleep deprivation and subsequent mental health comorbidities in patients with prurigo nodularis: A population-level analysis using the Health Improvement Network. E-poster presented at EADV 2023. Abstract available online
- Silverberg JI, et al. Phase 2B randomized study of nemolizumab in adults with moderate-to-severe atopic dermatitis and severe pruritus. J Allergy Clin Immunol. 2020;145(1):173-182. doi:10.1016/j.jaci.2019.08.013
- Bewley A, et al. Prurigo Nodularis: A Review of IL-31RA Blockade and Other Potential Treatments. Dermatol Ther (Heidelb). 2022;12(9):2039–2048. doi:10.1007/s13555- 022-00782-2
- Kwatra SG, Misery L, Clibborn C, Steinhoff M. Molecular and cellular mechanisms of itch and pain in atopic dermatitis and implications for novel therapeutics. Clin Transl Immunology. 2022;11(5):e1390. doi:10.1002/cti2.1390
- NEMLUVIO (nemolizumab-ilto) injection 30 mg Prescribing Information. Dallas, TX: Galderma Laboratories, L.P.; August 2024
- Oisín S, et al. 545 - Prevalence of moderate and severe atopic dermatitis in Ireland: a cross-sectional, real-world study of a secondary care population., BJD. 2024;190(S2): ii43–ii44. https://doi.org/10.1093/bjd/ljad498.045
- Silverberg JI, et al. Patient burden and quality of life in atopic dermatitis in US adults: a population-based cross-sectional study. Ann Allergy Asthma Immunol. 2018;121(3):340-347. doi:10.1016/j.anai.2018.07.006
- Penton H, et al. Assessing Response in Atopic Dermatitis: A Systematic Review of the Psychometric Performance of Measures Used in HTAs and Clinical Trials. Dermatol Ther (Heidelb). 2023;13(11):2549-2571. doi: 10.1007/s13555-023-01038-3
- Augustin M, et al. Real-World Treatment Patterns and Treatment Benefits among Adult Patients with Atopic Dermatitis: Results from the Atopic Dermatitis Patient Satisfaction and Unmet Need Survey. Acta Derm Venereol. 2022;7;102:adv00830. doi: 10.2340/actadv.v102.3932. PMID: 36479885; PMCID: PMC10508272.
- Durno, N, et al. Biologics and oral systemic treatment preferences in patients and physicians for moderate-to-severe atopic dermatitis: a discrete choice experiment in the United Kingdom and Germany. J Dermatol Treat. 2024; 35(1). https://doi.org/10.1080/09546634.2024.2417966
- Avena-Woods C. Overview of atopic dermatitis. Am J Manag Care. 2017;23(8 suppl):S115-S123. PMID:28978208
- Hahn EL, Bacharier LB. The atopic march: the pattern of allergic disease development in childhood. Immunol Allergy Clin North Am. 2005;25(2):231-46v doi:10.1016/j.iac.2005.02.004
- Chisolm SS. A Review of the Current Management and Burden of Prurigo Nodularis in the United States. AJMC. 2023;29(suppl 5):S63-S72. doi.org/10.37765/ajmc.2023.89366
- Lobefaro F, et al. Atopic Dermatitis: Clinical Aspects and Unmet Needs. Biomedicines. 2022;10: 2927. doi:10.3390/biomedicines10112927
- Silverberg J, et al. Nemolizumab with concomitant topical therapy in adolescents and adults with moderate-to-severe atopic dermatitis (ARCADIA 1 & 2): results from two replicate double-blinded, randomised controlled phase 3 trials. Lancet. 2024. doi: 10.1016/S0140-6736(24)01203-0
- Ständer S, et al. Nemolizumab monotherapy improves itch and skin lesions in patients with moderate-to-severe prurigo nodularis: Results from a global phase 3 trial (OLYMPIA 1): Late breaking abstract presented at EADV 2023
- Kwatra SG, et al. Placebo-controlled phase III trial of nemolizumab in patients with prurigo nodularis. N Engl J Med. 2023;389: 1579-89. doi: 10.1056/NEJMoa2301333
- Chugai Pharmaceutical Co., Ltd. Maruho Obtained Regulatory Approval for Mitchga, the first Antibody Targeting IL-31 for Itching Associated with Atopic Dermatitis. Available online. Accessed December 2024
- Chugai Pharmaceutical Co., Ltd. Mitchga Approved for Itching in Pediatric Atopic Dermati-tis and Prurigo Nodularis, for its Subcutaneous Injection 30mg Vials. Available online. Accessed December 2024
- ClinicalTrials.Gov. A Study to Assess the Efficacy and Safety of Nemolizumab (CD14152) in Participants With Prurigo Nodularis (PN). Available online. Accessed December 2024
- ClinicalTrials.Gov. An Efficacy and Safety Study of Nemolizumab (CD14152) in Participants With Prurigo Nodularis. Available online. Accessed December 2024
- Todberg T, et al. Treatment and burden of disease in a cohort of patients with prurigo nodularis: a survey-based study. Acta Derm Venereol. 2020;100(8): adv00119. doi:10.2340/00015555-3471
- Kwatra SG. Breaking the itch–scratch cycle in prurigo nodularis. N Engl J Med. 2020;382(8):757-758. doi:10.1056/NEJMe1916733
- ClinicalTrials.Gov. Efficacy and Safety of Nemolizumab in Subjects With Moderate-to-Severe Atopic Dermatitis (NCT03985943). Available online. Accessed December 2024
- ClinicalTrials.Gov. Efficacy & Safety of Nemolizumab in Subjects With Moderate-to-Severe Atopic Dermatitis (NCT03989349). Available online. Accessed December 2024
- Raharja A, et al. Psoriasis: a brief overview. Clin Med (Lond). 2021;21(3):170-173. doi: 10.7861/clinmed.2021-0257
- Katoh N, Ohya Y, Ikeda M, et al. Clinical practice guidelines for the management of atopic dermatitis 2018. J Dermatol. 2019;46(12):1053-1101. doi:10.1111/1346-8138.15090